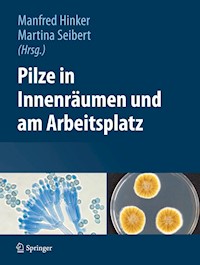
Pilze in Innenräumen und am Arbeitsplatz -  - E-Book

125,87 €
Dieses Buch geht der Frage nach, welche Rolle Pilze in der Arbeitswelt spielen, wie sie detektiert und identifiziert werden und welche gesundheitliche Bedeutung sie für den Menschen haben. „Unbeabsichtigt“ treten wir mit Schimmelpilzen zum Beispiel in Gebäuden, in der Landwirtschaft, der Abfallentsorgung und der metallverarbeitenden Industrie in Kontakt. Die „beabsichtigte Verwendung“ reicht von der Kultur der Speisepilze über den Einsatz von Mikropilzen in der Lebensmittel- und Pharmaindustrie bis zum Arbeiten in mikrobiologischen Laboratorien. Das Buch liefert fundierte Informationen über die unterschiedlichen Vorkommen und Anwendungen von Pilzen. Ein umfangreicher Bildteil gibt faszinierende Einblicke in die Schönheit der Pilze und Hilfestellung zu deren Identifizierung. Neben den klassischen Mess- und Analysemethoden werden auch die modernen chemischen und molekulargenetischen Verfahren vorgestellt.
Das E-Book können Sie in einer beliebigen App lesen, die das folgende Format unterstützt:
Veröffentlichungsjahr: 2013